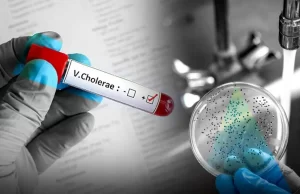
Salud Pública notifica aparición de 11 casos sospechosos de cólera

Redacción
Rosario proyecta alianza opositora no abarcaría todo el territorio de RD
Política.- El coordinador de la Comisión de Alianzas de la Fuerza del Pueblo, Roberto Rosario, proyectó que una alianza opositora se daría de manera...
Onamet: Onda tropical y vaguada seguirán provocando aguaceros
Tiempo.- La Oficina Nacional de Meteorología (Onamet) informó que una onda tropical ubicada sobre la porción central del país y la interacción de una...
Salud Pública notifica aparición de 11 casos sospechosos de cólera
Santo Domingo.- El Ministerio de Salud Pública a través del Viceministerio de Salud Colectiva y su Dirección General de Epidemiologia y la Dirección de...
Jean Alain desmiente sanciones de Agencia Española a RD por actos...
Santo Domingo.- El Consejo de Defensa de Jean Alain Rodríguez denunció que la Procuraduría General de la República envía noticias falsas a los medios...
La FAO señala que RD ha reducido la desnutrición y la...
Santo Domingo.- El Gobierno valoró este miércoles el informe de la Organización de las Naciones Unidas para la Alimentación y la Agricultura (FAO), que...
Contreras responde ataques de Salcedo: Dice no se le exigió renunciar...
Santo Domingo.- El precandidato a alcalde del Distrito Nacional, Domingo Contreras, dijo este miércoles que durante la gestión de Roberto Salcedo renunció como secretario...
El petróleo de Texas abre con una subida de 2,15 %,...
Economía.- El precio del barril de petróleo intermedio de Texas (WTI) abrió este miércoles con una subida del 2,15 %, hasta 71,29 dólares el...
Mantequilla busca hoy le sea variada medida de coerción
Santo Domingo.- Wilkin García Peguero, “Mantequilla” pidió este miércoles previo a la revisión de la medida de coerción en su contra una oportunidad a...
INABIE listo para suplir alimentos el próximo año escolar; pagó deudas...
Santo Domingo.- La actual gestión al frente del Instituto Nacional de Bienestar Estudiantil (INABIE) informó que solucionó los atrasos superiores a cuatro y hasta...
Amed Rosario da su HR 2 y remolca 4 vueltas en...
Deportes.- La temporada de Amed Rosario no ha sido nada fácil. En abril, el dominicano comenzó flojo, dejando promedio de .227. Y no le fue mucho...